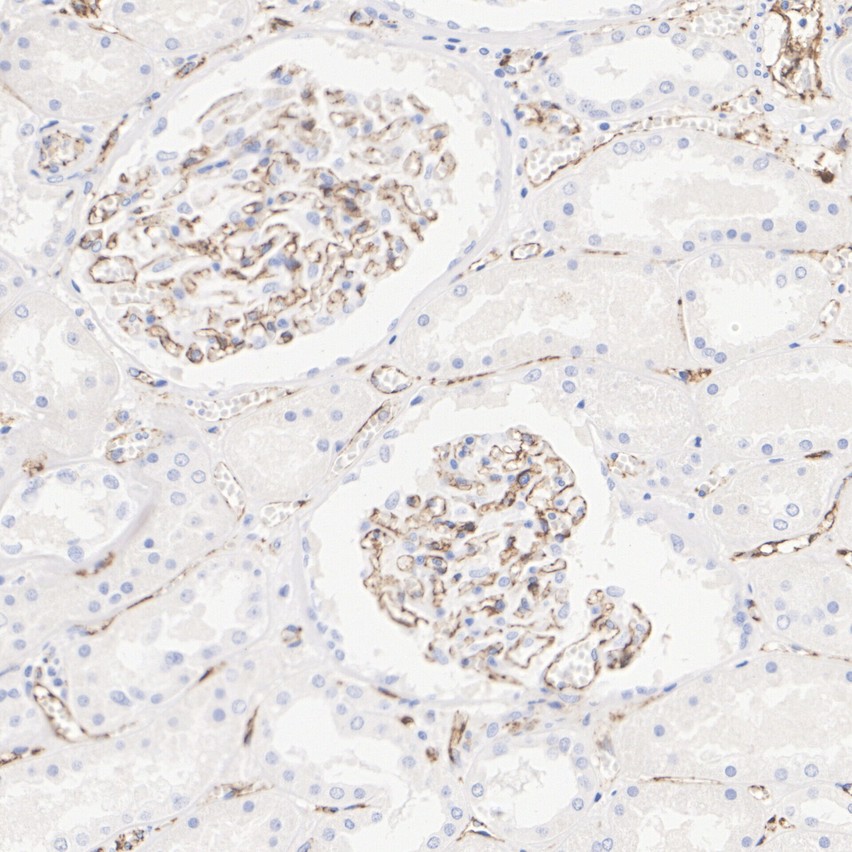

Rmb: 618 1500 特惠 1500
产品规格
Catalog# M1511-8
CD31 Mouse Monoclonal Antibody [7-A1]
-
WB
-
IF-Cell
-
IHC-P
-
mIHC
-
Human
-
unconjugated
Safety datasheet
概述
产品名称
CD31 Mouse Monoclonal Antibody [7-A1]
抗体类型
Mouse Monoclonal Antibody
免疫原
Synthetic peptide (KLH-coupled) within C-terminal residues of human CD31.
种属反应性
Human
验证应用
WB, IF-Cell, IHC-P, mIHC
分子量
Predicted band size: 83 kDa
阳性对照
THP-1 cell lysate, Jurkat cell lysate, U-937 cell lysate, human pancreatic carcinoma, human gastric cancer, THP-1, human appendix tissue, human placenta tissue, human uterus tissue, human striated muscle tissue, human kidney tissue, human liver tissue, human stomach cancer tissue, Jurkat, human lung squamous cell carcinoma tissue.
偶联
unconjugated
克隆号
7-A1
RRID
同源性数据

产品特性
形态
Liquid
浓度
存放说明
Shipped at 4℃. Store at +4℃ short term (1-2 weeks). It is recommended to aliquot into single-use upon delivery. Store at -20℃ long term.
存储缓冲液
1*TBS (pH7.4), 0.2% BSA, 50% Glycerol. Preservative: 0.05% Sodium Azide.
亚型
IgG2a
纯化方式
Immunogen affinity purified.
应用稀释度
-
WB
-
1:2,000-1:5,000
-
IF-Cell
-
1:100-1:200
-
IHC-P
-
1:500-1:2,000 (IF-Tissue is not recommended)
-
mIHC
-
1:1,000-1:3,000
靶点
功能
Cell adhesion molecules are a family of closely related cell surface glycoproteins involved in cell-cell interactions during growth and are thought to play an important role in embryogenesis and development. Neuronal cell adhesion molecule (NCAM) expression is observed in a variety of human tumors including neuroblastomas, rhabdomyosarcomas, Wilms’ tumors, Ewing’s sarcomas and some primitive myeloid malignancies. The intracellular adhesion molecule-1 (ICAM-1), also referred to as CD54, is an integral membrane protein of the immunoglobulin superfamily. PECAM-1 (platelet/endothelial cell adhesion molecule-1), also referred to as CD31, is a glycoprotein expressed on the cell surfaces of monocytes, neutrophils, platelets and a subpopulation of T cells. VCAM-1 (vascular cell adhesion molecule-1) was first identified as an adhesion molecule induced on human endothelial cells by inflammatory cytokines such as IL-1, tumor necrosis factor (TNF) and lipopolysaccharide (LPS). The KALIG gene encodes a nerve cell adhesion molecule (NCAM)-like protein and is deleted in 66% of patients with Kallmann’s syndrome, anosmia with secondary hypogonadism.
背景文献
1. Doi H et al. Potency of umbilical cord blood- and Wharton\'s jelly-derived mesenchymal stem cells for scarless wound healing. Sci Rep 6:18844 (2016).
2. Yang Y et al. The Increased Expression of Connexin and VEGF in Mouse Ovarian Tissue Vitrification by Follicle Stimulating Hormone. Biomed Res Int 2015:397264 (2015).
组织特异性
Expressed on platelets and leukocytes and is primarily concentrated at the borders between endothelial cells. Expressed in human umbilical vein endothelial cells (HUVECs) (at protein level). Expressed on neutrophils (at protein level). Isoform Long predominates in all tissues examined. Isoform Delta12 is detected only in trachea. Isoform Delta14-15 is only detected in lung. Isoform Delta14 is detected in all tissues examined with the strongest expression in heart. Isoform Delta15 is expressed in brain, testis, ovary, cell surface of platelets, human umbilical vein endothelial cells (HUVECs), Jurkat T-cell leukemia, human erythroleukemia (HEL) and U-937 histiocytic lymphoma cell lines (at protein level).
翻译后修饰
Phosphorylated on Ser and Tyr residues after cellular activation by src kinases. Upon activation, phosphorylated on Ser-729 which probably initiates the dissociation of the membrane-interaction segment (residues 709-729) from the cell membrane allowing the sequential phosphorylation of Tyr-713 and Tyr-690. Constitutively phosphorylated on Ser-734 in resting platelets. Phosphorylated on tyrosine residues by FER and FES in response to FCER1 activation (By similarity). In endothelial cells Fyn mediates mechanical-force (stretch or pull) induced tyrosine phosphorylation.; Palmitoylation by ZDHHC21 is necessary for cell surface expression in endothelial cells and enrichment in membrane rafts.
亚细胞定位
Cell junction. Cell membrane. Membrane.
别名
Adhesion molecule antibody
CD31 antibody
CD31 antigen antibody
CD31 EndoCAM antibody
EndoCAM antibody
FLJ34100 antibody
FLJ58394 antibody
GPIIA antibody
GPIIA' antibody
PECA1 antibody
展开Adhesion molecule antibody
CD31 antibody
CD31 antigen antibody
CD31 EndoCAM antibody
EndoCAM antibody
FLJ34100 antibody
FLJ58394 antibody
GPIIA antibody
GPIIA' antibody
PECA1 antibody
PECA1_HUMAN antibody
Pecam 1 antibody
PECAM 1 CD31 EndoCAM antibody
PECAM antibody
PECAM-1 antibody
Pecam1 antibody
Platelet and endothelial cell adhesion molecule 1 antibody
Platelet endothelial cell adhesion molecule antibody
Platelet/endothelial cell adhesion molecule 1 antibody
折叠图片
-

☑ Relative expression (RE)
Western blot analysis of CD31 on different lysates with Mouse anti-CD31 antibody (M1511-8) at 1/2,000 dilution.
Lane 1: THP-1 cell lysate
Lane 2: Jurkat cell lysate
Lane 3: U-937 cell lysate
Lane 4: HeLa cell lysate (negative)
Lane 5: MDA-MB-231 cell lysate (negative)
Lysates/proteins at 20 µg/Lane.
Predicted band size: 83 kDa
Observed band size: 130 kDa
Exposure time: 1 minute 58 seconds;
4-20% SDS-PAGE gel.
Proteins were transferred to a PVDF membrane and blocked with 5% NFDM/TBST for 1 hour at room temperature. The primary antibody (M1511-8) at 1/2,000 dilution was used in 5% NFDM/TBST at 4℃ overnight. Goat Anti-Mouse IgG - HRP Secondary Antibody (HA1006) at 1/50,000 dilution was used for 1 hour at room temperature. -

Fluorescence multiplex immunohistochemical analysis of the human gastric cancer (Formalin/PFA-fixed paraffin-embedded sections). Panel A: the merged image of anti-CD31 (M1511-8, red), anti-αSMA (ET1607-53, gray), anti-CD11b (ET1706-04, cyan), anti-panCK (HA601138, magenta) and anti-CD3 (HA720082, yellow) on human gastric cancer. Panel B: anti- CD31 stained on the endothelial cells. Panel C: anti-αSMA stained on cancer-associated fibroblasts and smooth muscle cells. Panel D: anti-CD11b stained on myeloid cells. Panel E: anti-panCK stained on cancer cells. Panel F: anti-CD3 stained on T cells. HRP Conjugated UltraPolymer Goat Polyclonal Antibody HA1119/HA1120 was used as a secondary antibody. The immunostaining was performed with the Sequential Immuno-staining Kit (IRISKit™MH010101, www.luminiris.cn). The section was incubated in five rounds of staining: in the order of M1511-8 (1/1,000 dilution), ET1607-53 (1/2,000 dilution), ET1706-04 (1/1,000 dilution), HA601138 (1/3,000 dilution), and HA720082 (1/500 dilution) for 20 mins at room temperature. Each round was followed by a separate fluorescent tyramide signal amplification system. Heat mediated antigen retrieval with Tris-EDTA buffer (pH 9.0) for 30 mins at 95℃. DAPI (blue) was used as a nuclear counter stain. Image acquisition was performed with Olympus VS200 Slide Scanner.
-

Fluorescence multiplex immunohistochemical analysis of the human gastric cancer (Formalin/PFA-fixed paraffin-embedded sections). Panel A: the merged image of anti-Ki67 (HA721115, red), anti-CD31 (M1511-8, green), anti-CD3 (HA720082, cyan), anti-panCK (HA601138, magenta) and anti-αSMA (ET1607-53, yellow) on human gastric cancer. Panel B: anti- Ki67 stained on cells in G1, S, G2 and M phases of cell cycle. Panel C: anti-CD31 stained on the endothelial cells. Panel D: anti-CD3 stained on T cells. Panel E: anti-panCK stained on cancer cells. Panel F: anti-αSMA stained on cancer-associated fibroblasts and smooth muscle cells. HRP Conjugated UltraPolymer Goat Polyclonal Antibody HA1119/HA1120 was used as a secondary antibody. The immunostaining was performed with the Sequential Immuno-staining Kit (IRISKit™MH010101, www.luminiris.cn). The section was incubated in five rounds of staining: in the order of HA721115 (1/2,000 dilution), M1511-8 (1/1,000 dilution), HA720082 (1/500 dilution), HA601138 (1/3,000 dilution), and ET1607-53 (1/2,000 dilution) for 20 mins at room temperature. Each round was followed by a separate fluorescent tyramide signal amplification system. Heat mediated antigen retrieval with Tris-EDTA buffer (pH 9.0) for 30 mins at 95℃. DAPI (blue) was used as a nuclear counter stain. Image acquisition was performed with Olympus VS200 Slide Scanner.
-

Fluorescence multiplex immunohistochemical analysis of the human pancreatic carcinoma (Formalin/PFA-fixed paraffin-embedded sections). Panel A: the merged image of anti-CD31 (M1511-8, green), anti-α-SMA (ET1607-53, red) and anti-FAP (ET1704-23, yellow) on human pancreatic carcinoma. Panel B: anti- CD31 stained on the endothelial cells. Panel C: anti-α-SMA stained on cancer-associated fibroblasts and smooth muscle cells. Panel D: anti-FAP stained on the cancer-associated fibroblasts. HRP Conjugated UltraPolymer Goat Polyclonal Antibody HA1119/HA1120 was used as a secondary antibody. The immunostaining was performed with the Sequential Immuno-staining Kit (IRISKit™MH010101, www.luminiris.cn). The section was incubated in three rounds of staining: in the order of M1511-8 (1/5,000 dilution), ET1704-23 (1/1,000 dilution), and ET1607-53 (1/3,000 dilution) for 20 mins at room temperature. Heat mediated antigen retrieval with Tris-EDTA buffer (pH 9.0) for 30 mins at 95℃. DAPI (blue) was used as a nuclear counter stain. Image acquisition was performed with Nikon ECLIPSE Ni-E microscope.
-

Fluorescence multiplex immunohistochemical analysis of human gastric cancer (Formalin/PFA-fixed paraffin-embedded sections). Panel A: the merged image of anti-CD11b (ET1706-04, Red), anti-CD3 (HA720082, Green) and anti-CD31 (M1511-8, Yellow) on human gastric cancer. HRP Conjugated UltraPolymer Goat Polyclonal Antibody HA1119/HA1120 was used as a secondary antibody. The immunostaining was performed with the Sequential Immuno-staining Kit (IRISKit™MH010101, www.luminiris.cn). The section was incubated in three rounds of staining: in the order of ET1706-04 (1/1,000 dilution), HA720082 (1/500 dilution) and M1511-8 (1/1,000 dilution) for 20 mins at room temperature. Each round was followed by a separate fluorescent tyramide signal amplification system. Heat mediated antigen retrieval with Tris-EDTA buffer (pH 9.0) for 30 mins at 95℃. DAPI (blue) was used as a nuclear counter stain. Image acquisition was performed with Zeiss Observer 7 Inverted Fluorescence Microscope.
-

Fluorescence multiplex immunohistochemical analysis of human kidney (Formalin/PFA-fixed paraffin-embedded sections). Panel A: the merged image of anti-CD31 (M1511-8, Red), anti-E-Cadherin (HA601143, Green), anti-Calbindin (ET1702-54, Magenta) on human kidney. HRP Conjugated UltraPolymer Goat Polyclonal Antibody HA1119/HA1120 was used as a secondary antibody. The immunostaining was performed with the Sequential Immuno-staining Kit (IRISKit™MH010101, www.luminiris.cn). The section was incubated in three rounds of staining: in the order of M1511-8 (1/1,000 dilution), HA601143 (1/4,000 dilution) and ET1702-54 (1/4,000 dilution) for 20 mins at room temperature. Each round was followed by a separate fluorescent tyramide signal amplification system. Heat mediated antigen retrieval with Tris-EDTA buffer (pH 9.0) for 30 mins at 95℃. DAPI (blue) was used as a nuclear counter stain. Image acquisition was performed with Olympus VS200 Slide Scanner.
-

Fluorescence multiplex immunohistochemical analysis of human gastric cancer (Formalin/PFA-fixed paraffin-embedded sections). Panel A: the merged image of anti-LC3B (ET1701-65, Green), anti-CD31 (M1511-8, Red) and anti-CA-IX (ET1701-51, Yellow) on human gastric cancer. HRP Conjugated UltraPolymer Goat Polyclonal Antibody HA1119/HA1120 was used as a secondary antibody. The immunostaining was performed with the Sequential Immuno-staining Kit (IRISKitCmTSA Kit 900802). The section was incubated in three rounds of staining: in the order of ET1701-65 (1/100 dilution), M1511-8 (1/2,000 dilution) and ET1701-51 (1/100 dilution) for 20 mins at room temperature. Each round was followed by a separate fluorescent tyramide signal amplification system. Heat mediated antigen retrieval with Tris-EDTA buffer (pH 9.0) for 30 mins at 95℃. DAPI (blue) was used as a nuclear counter stain. Image acquisition was performed with Olympus VS200 Slide Scanner.
-

Fluorescence multiplex immunohistochemical analysis of human liver (Formalin/PFA-fixed paraffin-embedded sections). Panel A: the merged image of anti-CD31(M1511-8, Red), anti-COL1A1(HA722517, Magenta) and anti-αSMA (ET1607-53, Yellow) on human liver. HRP Conjugated UltraPolymer Goat Polyclonal Antibody HA1119/HA1120 was used as a secondary antibody. The immunostaining was performed with the Sequential Immuno-staining Kit (IRISKit™MH010101, www.luminiris.cn). The section was incubated in three rounds of staining: in the order of M1511-8 (1/1000 dilution), HA722517 (1/10000 dilution) and ET1607-53 (1/5000 dilution) for 20 mins at room temperature. Each round was followed by a separate fluorescent tyramide signal amplification system. Heat mediated antigen retrieval with Tris-EDTA buffer (pH 9.0) for 30 mins at 95C. DAPI (blue) was used as a nuclear counter stain. Image acquisition was performed with Olympus VS200 Slide Scanner.
-

Immunohistochemical analysis of paraffin-embedded human appendix tissue with Mouse anti-CD31 antibody (M1511-8) at 1/2,000 dilution.
The section was pre-treated using heat mediated antigen retrieval with Tris-EDTA buffer (pH 9.0) for 20 minutes. The tissues were blocked in 1% BSA for 20 minutes at room temperature, washed with ddH2O and PBS, and then probed with the primary antibody (M1511-8) at 1/2,000 dilution for 1 hour at room temperature. The detection was performed using an HRP conjugated compact polymer system. DAB was used as the chromogen. Tissues were counterstained with hematoxylin and mounted with DPX. -

Immunohistochemical analysis of paraffin-embedded human placenta tissue with Mouse anti-CD31 antibody (M1511-8) at 1/2,000 dilution.
The section was pre-treated using heat mediated antigen retrieval with Tris-EDTA buffer (pH 9.0) for 20 minutes. The tissues were blocked in 1% BSA for 20 minutes at room temperature, washed with ddH2O and PBS, and then probed with the primary antibody (M1511-8) at 1/2,000 dilution for 1 hour at room temperature. The detection was performed using an HRP conjugated compact polymer system. DAB was used as the chromogen. Tissues were counterstained with hematoxylin and mounted with DPX. -

Immunohistochemical analysis of paraffin-embedded human uterus tissue with Mouse anti-CD31 antibody (M1511-8) at 1/1,500 dilution.
The section was pre-treated using heat mediated antigen retrieval with Tris-EDTA buffer (pH 9.0) for 20 minutes. The tissues were blocked in 1% BSA for 20 minutes at room temperature, washed with ddH2O and PBS, and then probed with the primary antibody (M1511-8) at 1/1,500 dilution for 1 hour at room temperature. The detection was performed using an HRP conjugated compact polymer system. DAB was used as the chromogen. Tissues were counterstained with hematoxylin and mounted with DPX. -

Immunohistochemical analysis of paraffin-embedded human striated muscle tissue with Mouse anti-CD31 antibody (M1511-8) at 1/1,000 dilution.
The section was pre-treated using heat mediated antigen retrieval with Tris-EDTA buffer (pH 9.0) for 20 minutes. The tissues were blocked in 1% BSA for 20 minutes at room temperature, washed with ddH2O and PBS, and then probed with the primary antibody (M1511-8) at 1/1,000 dilution for 1 hour at room temperature. The detection was performed using an HRP conjugated compact polymer system. DAB was used as the chromogen. Tissues were counterstained with hematoxylin and mounted with DPX. -

Immunohistochemical analysis of paraffin-embedded human kidney tissue with Mouse anti-CD31 antibody (M1511-8) at 1/2,000 dilution.
The section was pre-treated using heat mediated antigen retrieval with Tris-EDTA buffer (pH 9.0) for 20 minutes. The tissues were blocked in 1% BSA for 20 minutes at room temperature, washed with ddH2O and PBS, and then probed with the primary antibody (M1511-8) at 1/2,000 dilution for 1 hour at room temperature. The detection was performed using an HRP conjugated compact polymer system. DAB was used as the chromogen. Tissues were counterstained with hematoxylin and mounted with DPX. -

Immunohistochemical analysis of paraffin-embedded human liver tissue with Mouse anti-CD31 antibody (M1511-8) at 1/2,000 dilution.
The section was pre-treated using heat mediated antigen retrieval with Tris-EDTA buffer (pH 9.0) for 20 minutes. The tissues were blocked in 1% BSA for 20 minutes at room temperature, washed with ddH2O and PBS, and then probed with the primary antibody (M1511-8) at 1/2,000 dilution for 1 hour at room temperature. The detection was performed using an HRP conjugated compact polymer system. DAB was used as the chromogen. Tissues were counterstained with hematoxylin and mounted with DPX. -

Immunohistochemical analysis of paraffin-embedded human stomach cancer tissue with Mouse anti-CD31 antibody (M1511-8) at 1/2,000 dilution.
The section was pre-treated using heat mediated antigen retrieval with Tris-EDTA buffer (pH 9.0) for 20 minutes. The tissues were blocked in 1% BSA for 20 minutes at room temperature, washed with ddH2O and PBS, and then probed with the primary antibody (M1511-8) at 1/2,000 dilution for 1 hour at room temperature. The detection was performed using an HRP conjugated compact polymer system. DAB was used as the chromogen. Tissues were counterstained with hematoxylin and mounted with DPX. -

☑ Relative expression (RE)
Immunocytochemistry analysis of THP-1 (positive) and HeLa (negative) labeling CD31 with Mouse anti-CD31 antibody (M1511-8) at 1/100 dilution.
Cells were fixed in 4% paraformaldehyde for 20 minutes at room temperature, permeabilized with 0.1% Triton X-100 in PBS for 5 minutes at room temperature, then blocked with 1% BSA in 10% negative goat serum for 1 hour at room temperature. Cells were then incubated with Mouse anti-CD31 antibody (M1511-8) at 1/100 dilution in 1% BSA in PBST overnight at 4 ℃. Goat Anti-Mouse IgG H&L (iFluor™ 488, HA1125) was used as the secondary antibody at 1/1,000 dilution. PBS instead of the primary antibody was used as the secondary antibody only control. Nuclear DNA was labelled in blue with DAPI.
beta Tubulin (ET1602-4, red) was stained at 1/100 dilution overnight at +4℃. Goat Anti-Rabbit IgG H&L (iFluor™ 594, HA1122) were used as the secondary antibody at 1/1,000 dilution. -

mIHC analysis of human lung squamous cell carcinoma tissue (Formalin/PFA-fixed paraffin-embedded sections) with Mouse anti-CD31 antibody (M1511-8) at 1/2,000 dilution. The immunostaining was performed with the IRISKitCmTSA Kit (900809). Heat mediated antigen retrieval with Tris-EDTA buffer (pH 9.0) for 30 mins at 95℃. DAPI (blue) was used as a nuclear counter stain. Image acquisition was performed with Olympus VS200 Slide Scanner.
-

Immunohistochemical analysis of paraffin embedded human liver tissue using anti-CD31 antibody (1/200) performed on the Ventana® BenchMark ULTRA.
-

Immunohistochemical analysis of paraffin embedded human liver tissue using anti-CD31 antibody (1/200) performed on the Dako Omnis.
请注意: All products are "FOR RESEARCH USE ONLY AND ARE NOT INTENDED FOR DIAGNOSTIC OR THERAPEUTIC USE"
引文
-
Single-cell RNA Sequencing Discovered Subtypes Associated with Angiogenesis and Propranolol Treatment in Infantile Hemangioma
期刊: Genomics Proteomics & Bioinformatics
DOI: 10.1093/gpbjnl/qzag023
IF: 7.9
应用: IF-tissue
反应种属: Human
发表时间: 2026 Mar
-
Selective targeting of endothelial and perivascular angiocrine ROCK2 treats liver fibrosis
期刊: Cell
DOI: 10.1016/j.cell.2026.02.001
IF: 42.5
应用: mIF
反应种属: Human
发表时间: 2026 Mar
-
Adhesive Microneedle-Nanosheets With Temporally Orchestrated Antimicrobial, Immunomodulatory, and Osteogenic Functions for Periodontal Regeneration
期刊: Advanced Materials
DOI: 10.1002/adma.72919
IF: 26.8
应用: IF-tissue
反应种属: Rat
发表时间: 2026 Mar
-
Multi-omics causal inference unravels arterial BCAR1 as a novel protective factor against intracranial aneurysm
期刊: International Journal of Surgery
DOI: 10.1097/JS9.0000000000005004
IF: 10.1
应用: mIF
反应种属: Human
发表时间: 2026 Mar
-
Photothermally Activated Multifunctional Hydrogel with Bioactive Carbon Nanomaterials for Accelerated Diabetic Wound Healing
期刊: ACS Applied Materials & Interfaces
DOI: 10.1021/acsami.6c03986
IF: 8.2
应用: WB
反应种属: Human
发表时间: 2026 Mar
-
NMN prevents obesity-induced osteoporosis by promoting mitophagy to restore type H vessels
期刊: Biochemical Pharmacology
DOI: 10.1016/j.bcp.2026.117839
IF: 5.6
应用: IF-cell
反应种属: Mouse
发表时间: 2026 Feb
-
Novel Rapid In Situ Curable PEGDA/PEG Composite Hydrogel Drives Biological Closure of Aneurysm Neck
期刊: ACS Omega
DOI: 10.1021/acsomega.5c09657
IF: 4.3
应用: IF-cell,WB
反应种属: Human
发表时间: 2026 Feb
-
MFG-E8 in Kawasaki Disease: Role in Endothelial Injury and Diagnostic Potential
期刊: Journal Of Inflammation Research
DOI: 10.2147/JIR.S547634
IF: 4.1
应用: mIHC
反应种属: Mouse
发表时间: 2025 Nov
-
Paris saponin VII restrains PD-L1 mediated immune evasion through the AKT1 and STAT3 signaling pathways
期刊: Chemico-Biological Interactions
DOI: 10.1016/j.cbi.2025.111562
IF: 4.7
应用: IHC-P
反应种属: Mouse
发表时间: 2025 May
-
Penetrative Biomimetic Nanovehicle Boosts Immunotherapy in Triple-Negative Breast Cancer via SOS1 Blockade
期刊: Asian Journal of Pharmaceutical Sciences
DOI: 10.1016/j.ajps.2025.101064
IF: 10.7
应用: IF-tissue
反应种属: Mouse
发表时间: 2025 May
-
Tumor suppressor SLC9A2 inhibits colorectal cancer metastasis and reverses immunotherapy resistance by suppressing angiogenesis
期刊: Journal Of Experimental & Clinical Cancer Research
DOI: 10.1186/s13046-025-03422-7
IF: 12.8
应用: IHC-P
反应种属: Mouse,Human
发表时间: 2025 Jun
-
Incorporating Stem Cell-Derived Small Extracellular Vesicles into a Multifunctional OHAMA-EPL Hydrogel Spray for Rapid Healing of Infected Skin Wounds
期刊: Advanced Healthcare Materials
DOI: 10.1002/adhm.202404147
IF: 9.6
应用: IHC
反应种属: Mouse
发表时间: 2025 Jul
-
Traditional Chinese Medicine Borneol-Based Polymeric Micelles Intracerebral Drug Delivery System for Precisely Pathogenesis-Adaptive Treatment of Ischemic Stroke
期刊: Advanced Science
DOI:
IF: 14.3
应用: IF-cell
反应种属: Mouse
发表时间: 2025 Jan
-
Ischemic Area-Targeting and Self-Monitoring Nanoprobes Ameliorate Myocardial Ischemia/Reperfusion Injury by Scavenging ROS and Counteracting Cardiac Inflammation
期刊: Advanced Science
DOI: 10.1002/advs.202414518
IF: 14.1
应用: IF-Tissue
反应种属: Mouse
发表时间: 2025 Jan
-
Constructing a 3D co-culture in vitro synovial tissue model for rheumatoid arthritis research
期刊: Materials Today Bio
DOI:
IF: 8.7
应用: IF-cell
反应种属: Human
发表时间: 2025 Jan
-
Traditional Chinese Medicine Borneol-Based Polymeric Micelles Intracerebral Drug Delivery System for Precisely Pathogenesis-Adaptive Treatment of Ischemic Stroke
期刊: Advanced Science
DOI: 10.1002/advs.202410889
IF: 14.1
应用: IF-Tissue
反应种属: Mouse
发表时间: 2025 Jan
-
Constructing a 3D co-culture in vitro synovial tissue model for rheumatoid arthritis research
期刊: Materials Today Bio
DOI: 10.1016/j.mtbio.2025.101492
IF: 10.2
应用: IF-Cell
反应种属: Human
发表时间: 2025 Jan
-
Reversibly unlocking the blood–brain barrier: A study on microtubule dynamics modulation using gold nanoparticle-modified reduced graphene oxide
期刊: Acta Pharmaceutica Sinica B
DOI: 10.1016/j.apsb.2025.12.015
IF: 14.6
应用: IF-tissue
反应种属: Mouse
发表时间: 2025 Dec
-
Dual-tDCS Ameliorates Cerebral Injury and Promotes Motor Function Recovery via cGAS-STING Signaling Pathway in a Rat Model of Ischemic Stroke
期刊: Molecular Neurobiology
DOI:
IF: 4.6
应用: WB
反应种属: Rat
发表时间: 2024 Oct
-
Microenvironment-responsive injectable hydrogel for neuro-vascularized bone regeneration
期刊: Materials Today Bio
DOI:
IF:
应用: IHC-P
反应种属: Rat
发表时间: 2024 Nov
-
CENPF May Act as a Novel Marker and Highlight the Influence of Pericyte in Infantile Hemangioma
期刊: Angiology
DOI:
IF: 2.6
应用: IF-cell
反应种属: Human
发表时间: 2024 Jun
-
Gelatin‑sodium alginate composite hydrogel doped with black phosphorus@ZnO heterojunction for cutaneous wound healing with antibacterial, immunomodulatory, and angiogenic properties
期刊: International Journal Of Biological Macromolecules
DOI:
IF: 7.7
应用: WB
反应种属: Human
发表时间: 2024 Jul
-
Integrating RNA-sequencing and network analysis to explore the mechanism of topical Pien Tze Huang treatment on diabetic wounds
期刊: Frontiers In Pharmacology
DOI: 10.3389/fphar.2023.1288406
IF: 4.4
应用: IF-tissue
反应种属: Rat
发表时间: 2024 Jan
-
Serum apelin as a potential biomarker for infantile hemangiomas
期刊: Pediatric Blood & Cancer
DOI:
IF: 3.2
应用: IF-cell
反应种属: Human
发表时间: 2024 Apr
-
Efficacy and safety of apatinib combined with dose-dense paclitaxel and carboplatin in neoadjuvant therapy for locally advanced triple-negative breast cancer: A prospective cohort study with propensity-matched analysis
期刊: International Journal Of Cancer
DOI: 10.1002/ijc.34717
IF: 6.4
应用: IHC-P
反应种属: Human
发表时间: 2023 Sept
-
Panax Quinquefolium Saponins enhances angiogenesis in rats with diabetes and myocardial infarction
期刊: Journal Of Ethnopharmacology
DOI: 10.1016/j.jep.2023.117252
IF: 5.4
应用: IF-tissue
反应种属: Rat
发表时间: 2023 Sept
-
Hypoxia Drives Material-Induced Heterotopic Bone Formation by Enhancing Osteoclastogenesis via M2/Lipid-Loaded Macrophage Axis
期刊: Advanced Science
DOI:
IF:
应用: IF-tissue
反应种属: Mouse
发表时间: 2023 May
-
Preparation of Ultra-Small Copper Nanoparticles-Loaded Self-Healing Hydrogels with Antibacterial, Inflammation-Suppressing and Angiogenesis-Enhancing Properties for Promoting Diabetic Wound Healing
期刊: International Journal Of Nanomedicine
DOI:
IF: 8.0
应用: IF-cell
反应种属: Human
发表时间: 2023 Jun
-
Self-powered enzyme-linked microneedle patch for scar-prevention healing of diabetic wounds
期刊: Science Advances
DOI:
IF: 13.6
应用: IHC-P
反应种属: Rat
发表时间: 2023 Jul
-
Novel hKDR mouse model depicts the antiangiogenesis and apoptosis‐promoting effects of neutralizing antibodies targeting vascular endothelial growth factor receptor 2
期刊: Cancer Science
DOI:
IF: 6.518
应用: IF-tissue
反应种属: Mouse
发表时间: 2023 Jan
-
Lipofectamine 2000/siRNA complexes cause endoplasmic reticulum unfolded protein response in human endothelial cells. Journal of cellular physiology, 234(11), 21166–21181.
期刊: Journal Of Cellular Physiology
DOI:
IF: 4.522
应用: WB
反应种属: Human
发表时间: 2019 Nov
同靶点 & 同通路的产品
CD31 Rabbit Polyclonal Antibody
Application: WB,IF-Cell,FC,IHC-P
Reactivity: Human,Mouse,Rat
Conjugate: unconjugated
CD31 Recombinant Antibody - Rabbit IgG (Chimeric)
Application: mIHC
Reactivity: Human
Conjugate: unconjugated
CD31 Recombinant Rabbit Monoclonal Antibody [SU03-59] - BSA and Azide free
Application: WB,IHC-P,FC,IP,IF-Cell,IF-Tissue
Reactivity: Human
Conjugate: unconjugated
CD31 Recombinant Antibody [7-A1-R] - Rabbit IgG (Chimeric) - BSA and Azide free
Application: WB,IF-Cell,IHC-P,FC
Reactivity: Human
Conjugate: unconjugated
CD31 Recombinant Rabbit Monoclonal Antibody [PSH20-35] - BSA and Azide free
Application: IHC-P
Reactivity: Human,Mouse,Rat
Conjugate: unconjugated
CD31 Recombinant Antibody [7-A1-R] - Rabbit IgG (Chimeric)
Application: WB,IF-Cell,IHC-P,FC,mIHC
Reactivity: Human
Conjugate: unconjugated
CD31 Recombinant Antibody [7-A1-R] - Rat IgG1 (Chimeric) - BSA and Azide free
Application: IHC-P
Reactivity: Human
Conjugate: unconjugated
CD31 Recombinant Rabbit Monoclonal Antibody [SU03-59]
Application: WB,IHC-P,FC,IP,IF-Cell,IF-Tissue
Reactivity: Human
Conjugate: unconjugated
Human CD31 Recombinant Rabbit Monoclonal Antibody [PSH07-82] - BSA and Azide free (Capture)
Application: ELISA(Cap)
Reactivity: Human
Conjugate: unconjugated
CD31 Recombinant Mouse Monoclonal Antibody [7-A1-R] - BSA and Azide free
Application: WB,IF-Cell,IHC-P
Reactivity: Human
Conjugate: unconjugated
Human CD31 Recombinant Rabbit Monoclonal Antibody [PSH07-83] - BSA and Azide free (Detector)
Application: ELISA(Det)
Reactivity: Human
Conjugate: unconjugated
Biotin Conjugated Human CD31 Recombinant Rabbit Monoclonal Antibody [PSH07-83] - Detector
Application: ELISA(Det)
Reactivity: Human
Conjugate: Biotin
CD31 Mouse Monoclonal Antibody
Application: mIHC
Reactivity: Human
Conjugate: unconjugated
CD31 Recombinant Antibody [7-A1-R] - Rat IgG1 (Chimeric)
Application: IHC-P
Reactivity: Human
Conjugate: unconjugated
CD31 Recombinant Rabbit Monoclonal Antibody [PSH20-35]
Application: IHC-P
Reactivity: Human,Mouse,Rat
Conjugate: unconjugated
iFluor™ 488 Conjugated CD31 Recombinant Rabbit Monoclonal Antibody [SU03-59]
Application: IF-Tissue
Reactivity: Human
Conjugate: iFluor™ 488
CD31 Recombinant Mouse Monoclonal Antibody [7-A1-R]
Application: WB,IF-Cell,IHC-P
Reactivity: Human
Conjugate: unconjugated

浙公网安备 33019202000643号
浙公网安备 33019202000643号